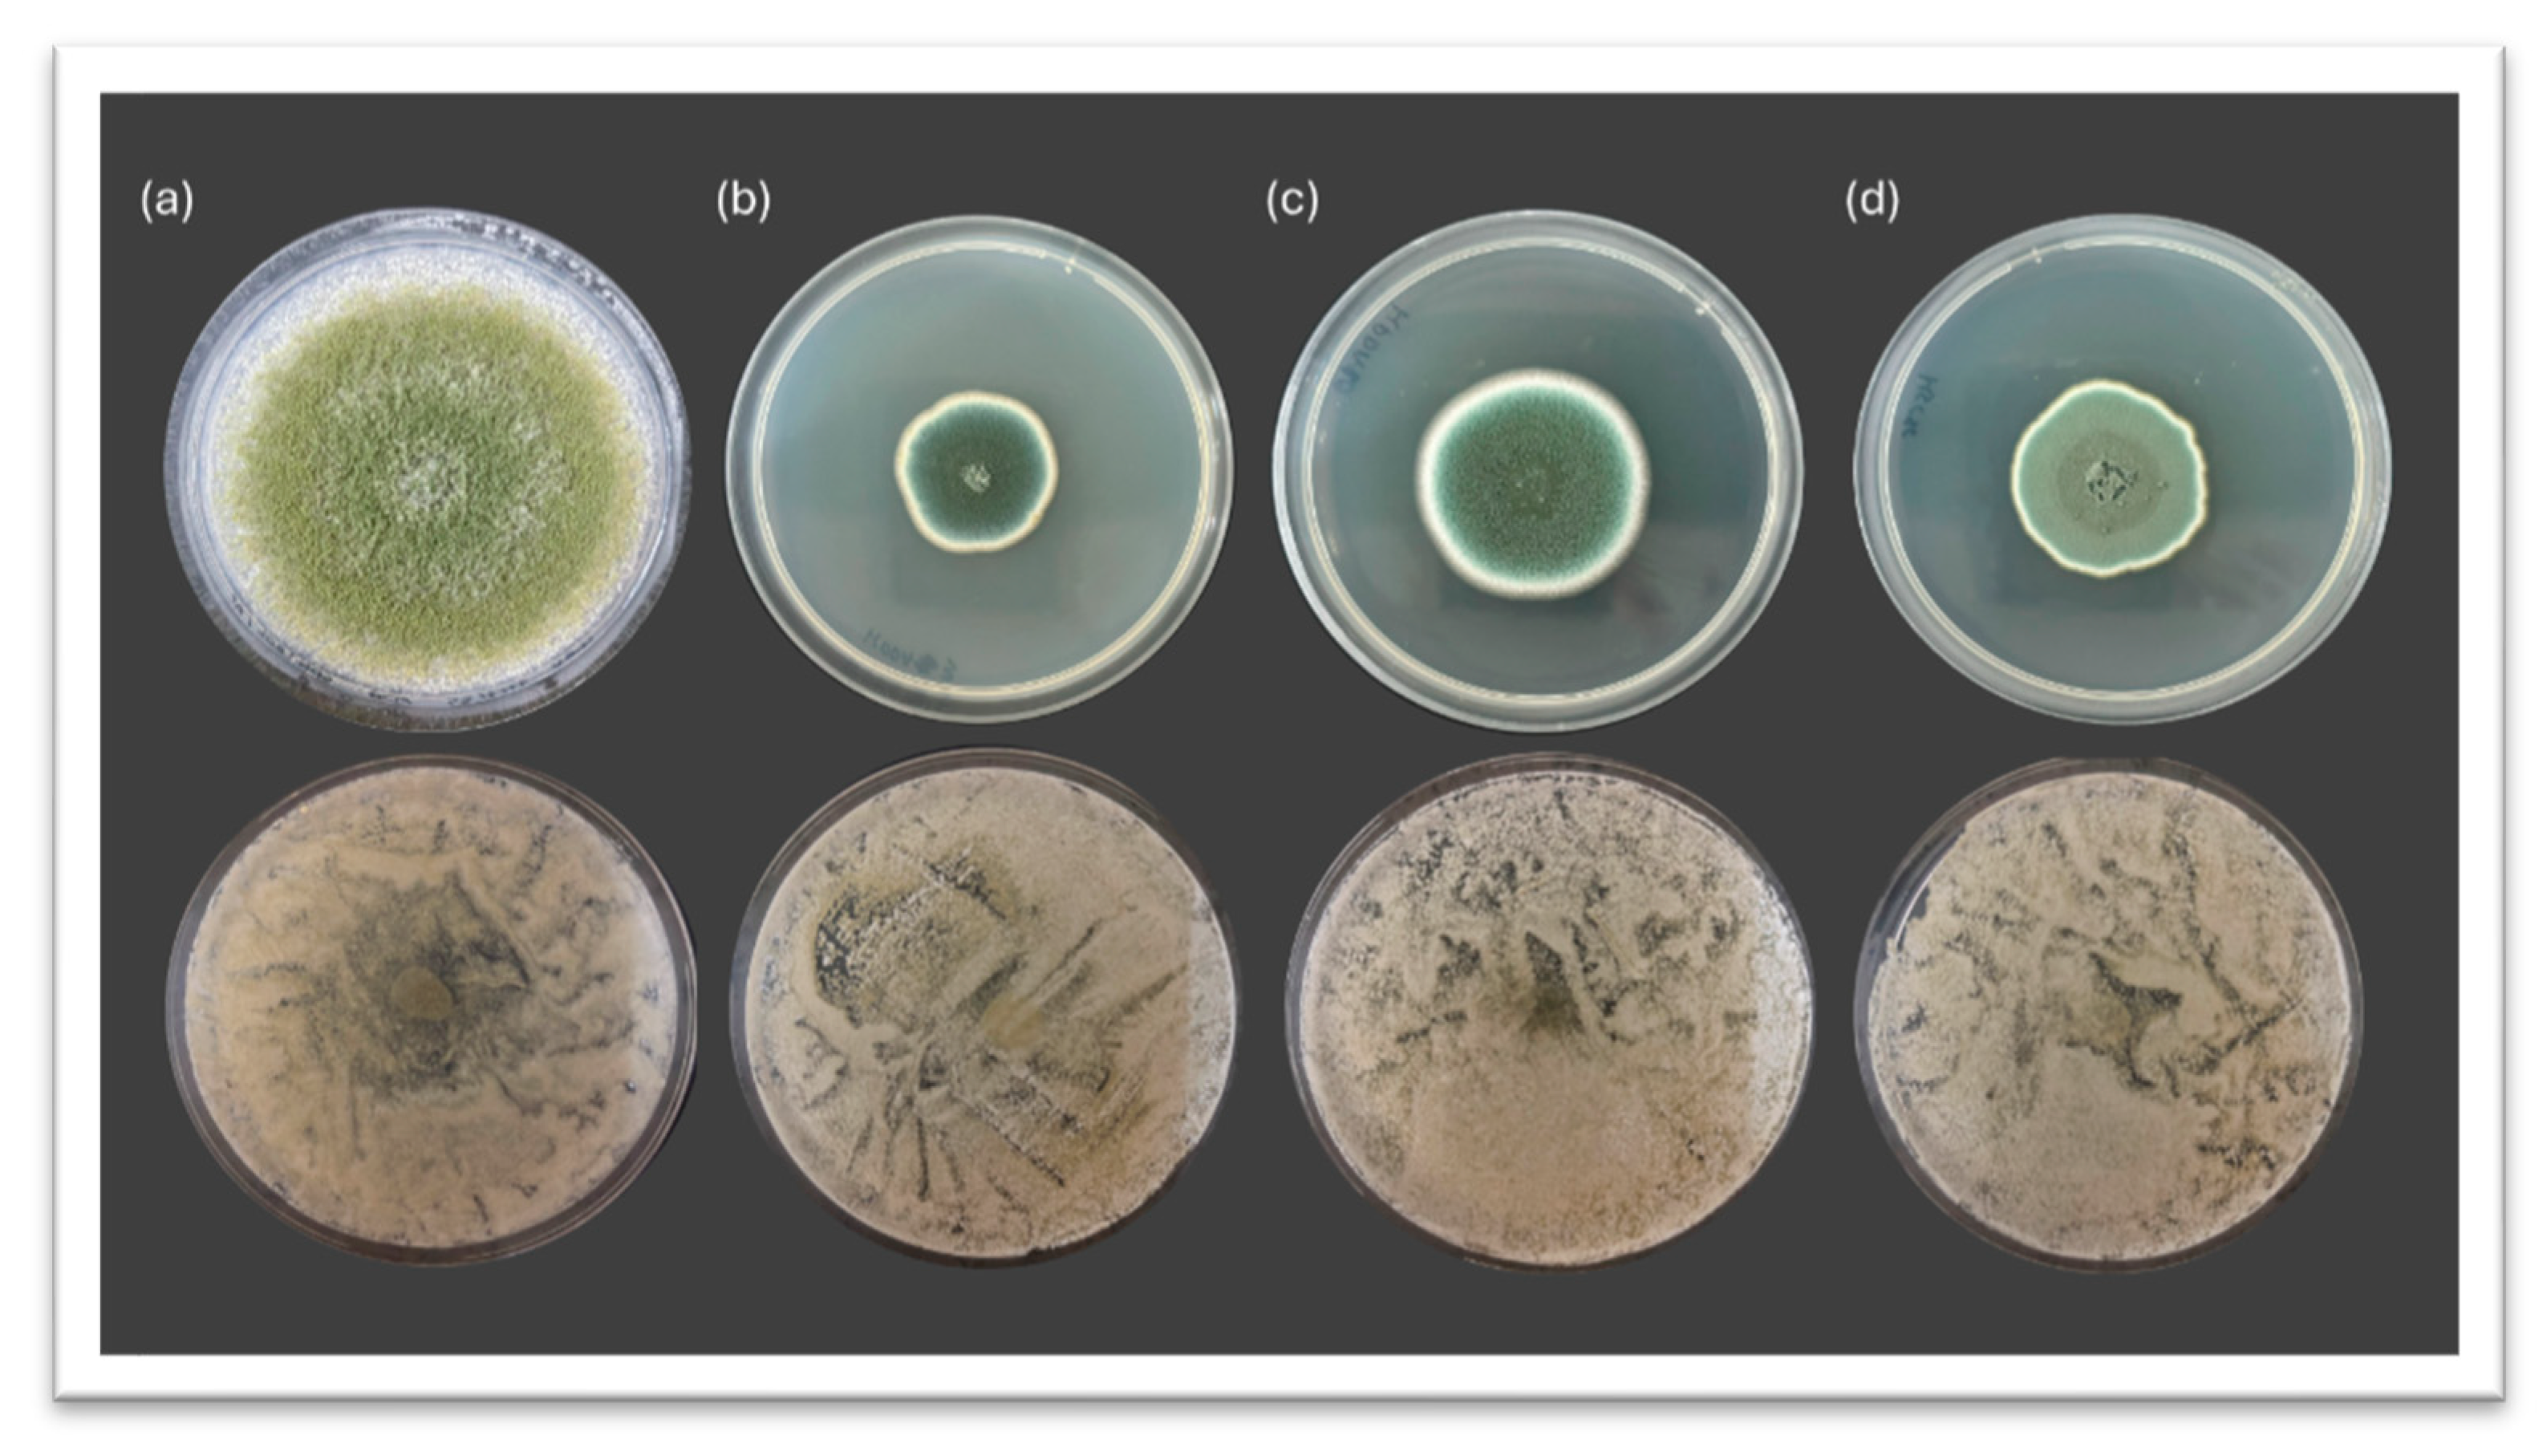
Preprints 173075 g001
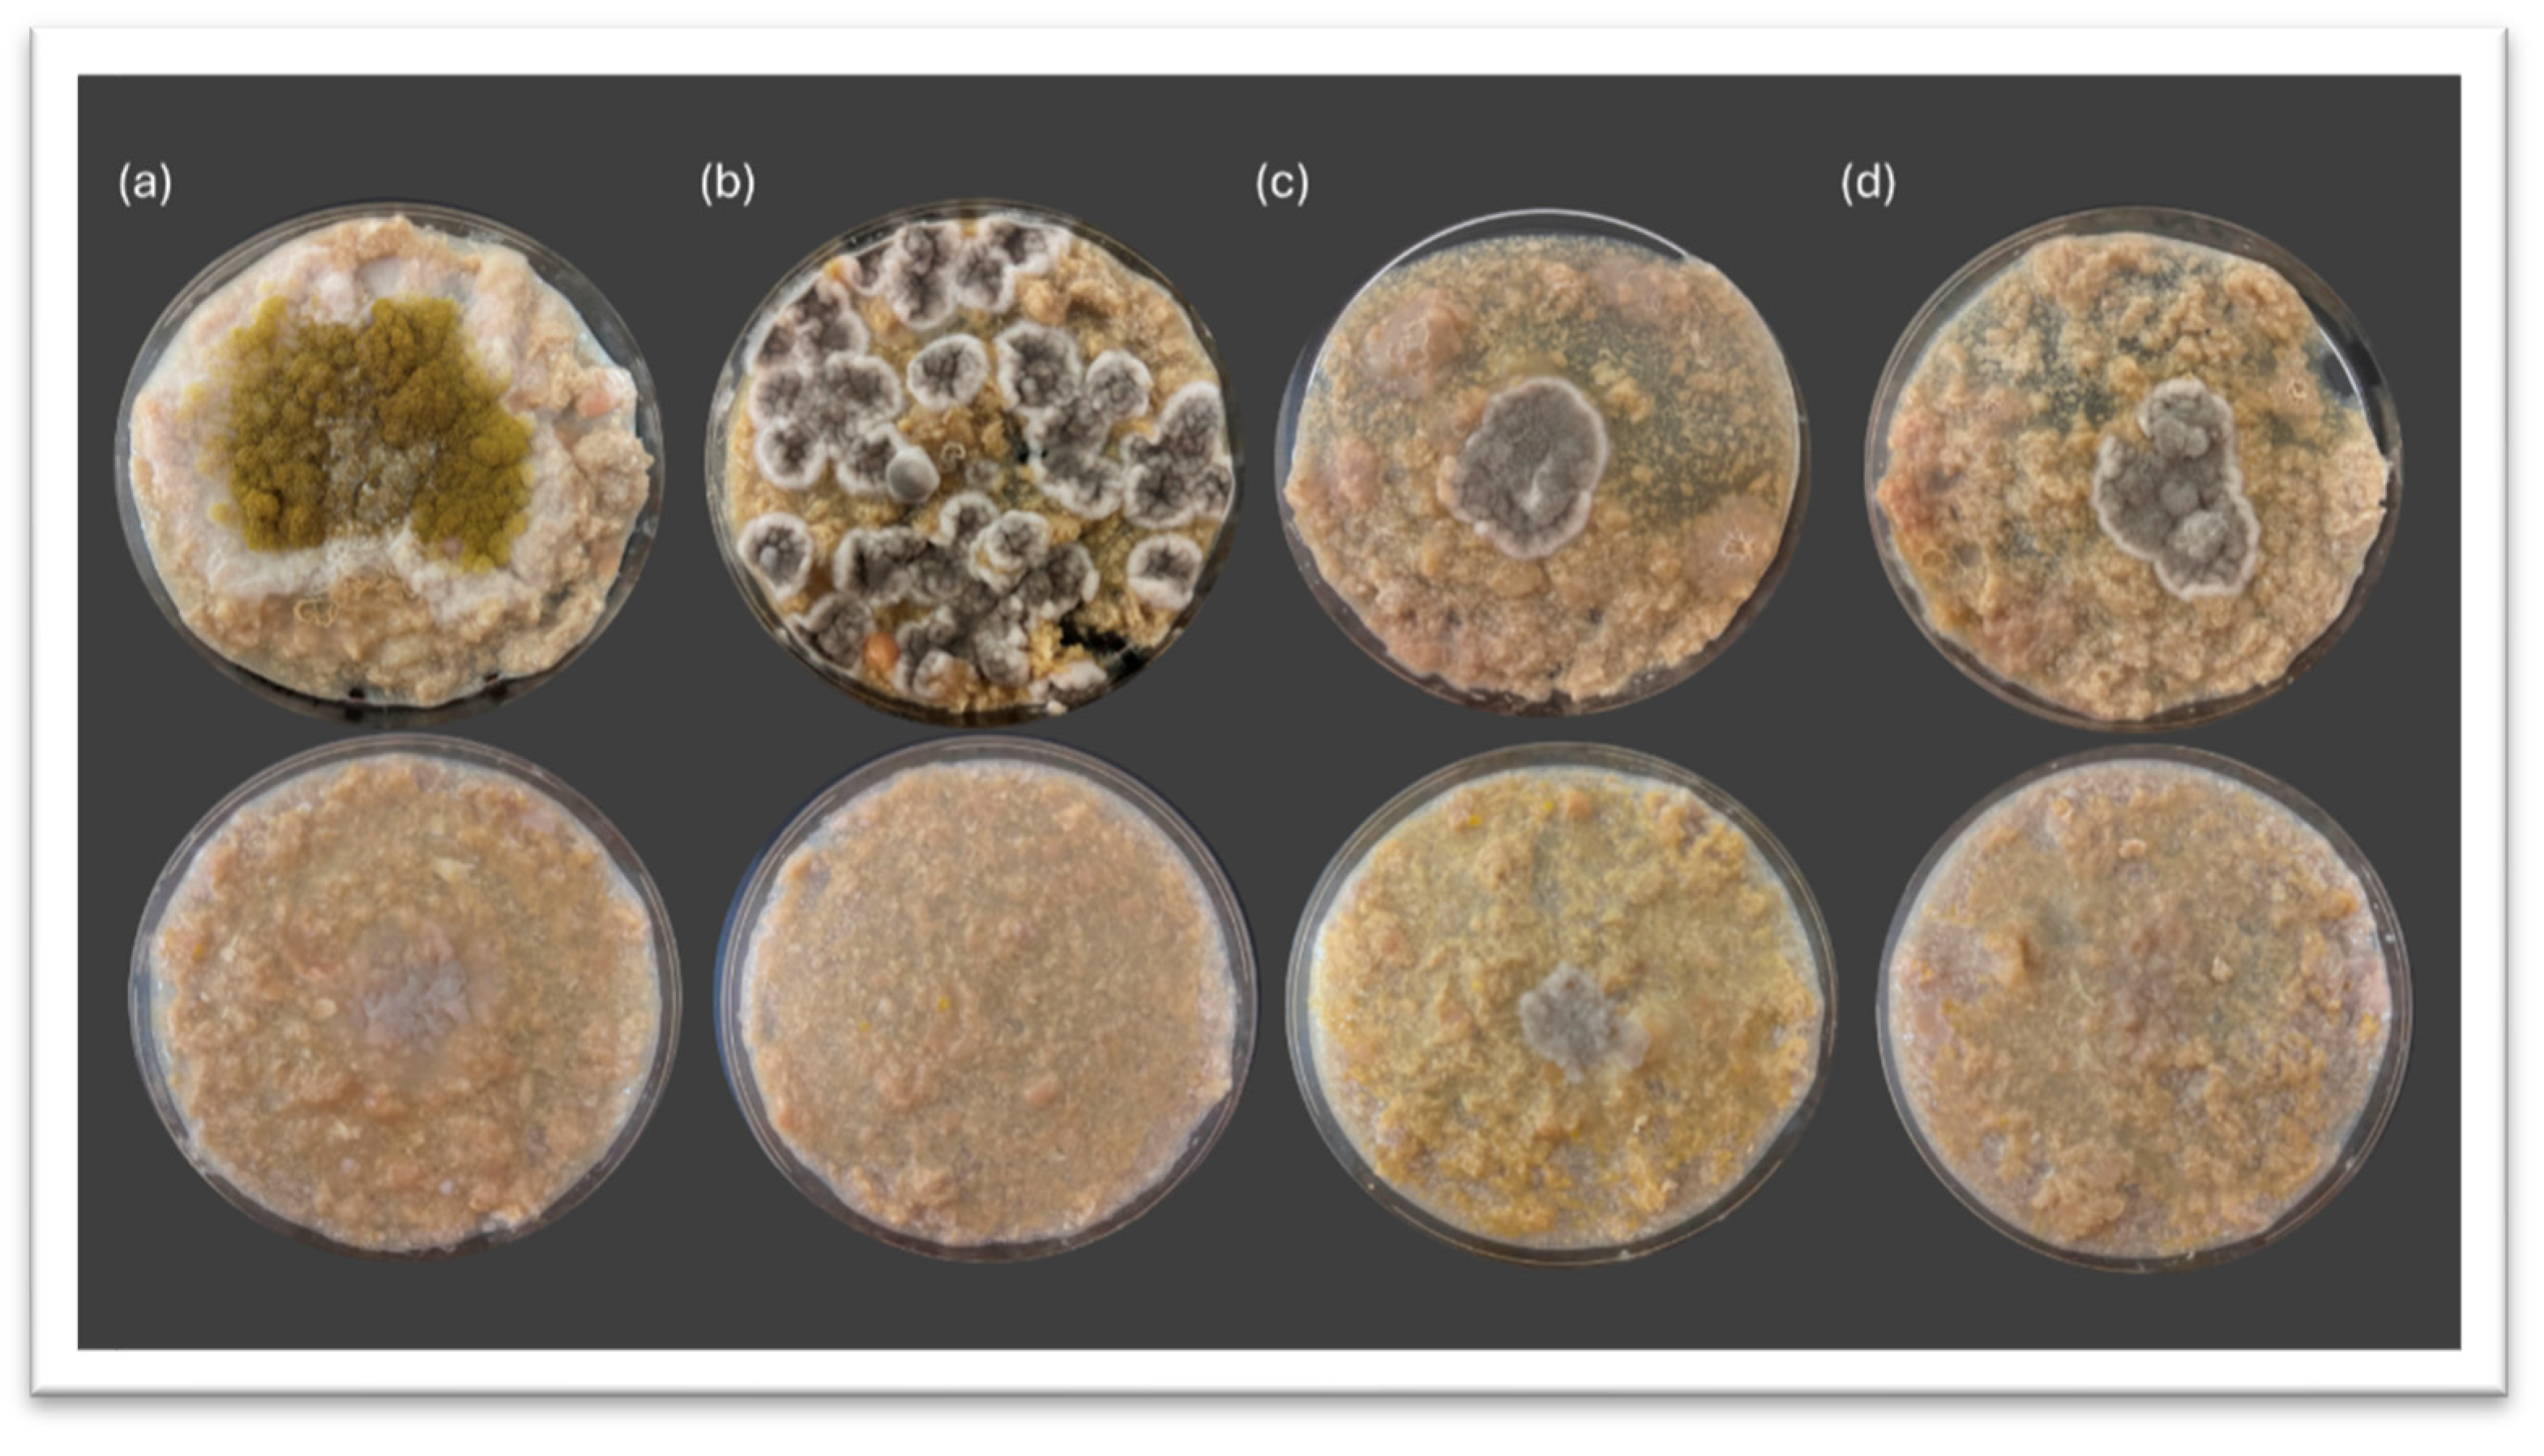
Preprints 173075 g003

1. Introduction
In recent years, the growing consumer demand for safer and healthier food products has driven the industry to reduce or replace synthetic additives with natural alternatives. One of the primary consequences of this transition is the increased vulnerability of food matrices to microbial spoilage, particularly by filamentous fungi capable of altering the characteristics of the product, resulting in a reduction of its quality in terms of food safety and organoleptic qualities. Among the strategies explored to address this issue, the use of biocontrol agents has gained relevance due to their ability to act synergistically with existing preservation technologies while maintaining the overall quality of the food product [
1,
2,
3,
4,
5].
Yeasts have emerged as promising candidates in this context due to their versatility, resilience, and ability to antagonize spoilage fungi through multiple mechanisms, including competition for nutrients and space, secretion of antifungal metabolites, biofilm formation, and production of volatile organic compounds (VOCs) [
6,
7,
8]. Within this group,
Debaryomyces hansenii stands out as a non-conventional yeast frequently isolated from salted and fermented foods, particularly dry-cured meat products and cheeses [
1,
4,
9,
10,
11]. Its tolerance to high salt, low pH, and oxidative stress, along with its contribution to the sensory development of food products, makes it an excellent candidate for inclusion in integrated biopreservation systems [
12,
13,
14,
15,
16,
17].
D. hansenii belongs to the CTG clade of hemiascomycetous yeasts and exhibits genomic and physiological traits that clearly distinguish it from other model organisms such as
Saccharomyces cerevisiae [
18,
19]. It shows remarkable genetic variability among strains, including differences in chromosome number and gene content [
20,
21], which may account for its strain-dependent efficacy as a biocontrol agent [
4,
22]. Moreover, the European Food Safety Authority (EFSA) includes
D. hansenii in its Qualified Presumption of Safety (QPS) list, supporting its safe use in food fermentation and preservation processes [
23]. Several studies have demonstrated the effectiveness of
D. hansenii in inhibiting common spoilage fungi in food, including species of
Penicillium,
Aspergillus,
Mucor, and
Fusarium, through diverse antagonistic strategies [
4,
6,
22,
24,
25,
26]. In dry-cured meat products, some of these molds pose a particular risk, as they can cause sensory defects or accumulate undesirable metabolites, especially under conditions with reduced preservative content that may favor fungal proliferation [
27].
D. hansenii exerts its antifungal activity through a complex combination of mechanisms, the relative contribution of which has not yet been fully elucidated. Although this yeast is widely recognized as having a multifactorial nature in its antagonistic potential, most available studies have focused only on isolated aspects of its mode of action. Commonly described strategies include biofilm formation on food surfaces, which acts as a physical barrier against fungal colonization; competition for essential nutrients and ecological space, thereby limiting resource availability for spoilage fungi [
6,
7,
22,
26]; and the potential production of toxic compounds, such as killer proteins or other molecules with direct antifungal effects [
28,
29,
30,
31]. However, a deeper and integrated investigation of these mechanisms under controlled conditions and within real food matrices is still necessary to more accurately determine the key factors driving its efficacy as a biocontrol agent. Furthermore, the food matrix itself can strongly influence the expression of antifungal properties by
D. hansenii. While synthetic media allow higher reproducibility in in vitro assays, they do not faithfully reproduce the physicochemical complexity of real products. When
D. hansenii is cultivated in media prepared with cured meat, significant differences have been observed in both the volatile compound profile and the degree of fungal inhibition [
32]. These findings underscore the need to design in vitro experimental systems that realistically simulate the target food product.
In the present study, a comparison of the antifungal potential of several D. hansenii strains isolated from cured Iberian pork loin was performed, focusing on their ability to inhibit representative spoilage molds under in vitro conditions. Two experimental systems were employed: PDA (Potato Dextrose Agar) plates and a semi-synthetic medium prepared with homogenized Iberian pork loin and water. This dual approach allowed us to investigate whether the composition of the medium influences the antagonistic activity of D. hansenii against different spoilage molds associated with dry-cured Iberian pork loin. The results obtained portrayed the relevance of early inclusion on food-based media when working in application studies to the food industry.
2. Materials and Methods
2.1. Biological Material and Culture Conditions
D. hansenii and mold strains used in this study were previously isolated from traditionally dry-cured Iberian pork loin (“
Lomo ibérico curado”) produced in the Los Pedroches region (Córdoba, Spain) and maintained in the strain collection of the Department of Agricultural Chemistry, Edaphology and Microbiology at the University of Córdoba. The laboratory wild-type strain CBS767 (Fungal Biodiversity Center, The Netherlands) was also used as control (
Table 1).
For experimental assays, all yeast and mold strains were grown on Yeast Extract Peptone Dextrose Agar (YPDA; 1% yeast extract, 2% peptone, 2% D-glucose, and 2% agar) or Potato Dextrose Agar (PDA; 39 g/L OXOID, Basingstoke, Hampshire, UK) and incubated at 26 °C. To simulate food-like conditions, a custom semi-synthetic meat-derived (Iberian cured pork loin) media (LBM) was prepared by homogenizing cured Iberian pork loin in sterile distilled water (20% w/v) and 2% agar.
2.2. Evaluation of the Antifungal Potential of D. hansenii Against Undesirable Molds
The antagonistic activity of D. hansenii strains was assessed under in vitro conditions using two solid media: (i) standard PDA and (ii) LBM autoclaved at 121 °C for 20 min. Yeast suspensions were adjusted to 106 CFU/mL by Neubauer chamber cell counting and 100 µL were evenly spread onto the surface of each plate. After, 10 µL of mold spore suspension (104 spores/mL) was inoculated at the center of each plate. Plates were incubated at 26 °C for 72 h, and mold growth was monitored daily.
2.3. Data Quantification and Statistical Analysis
All experiments were repeated at least three times, and three technical replicates for each sample were performed. Inhibitory activity was quantified by measuring the radial expansion of the mold colony using ImageJ software (v1.53) and calculating the inhibition percentage (IA) with the following formula:
Where C corresponds to the average diameter of the mold colony in the absence of yeast (control), and T is the diameter observed in co-cultivation with D. hansenii.
To determine whether the inhibition achieved by each D. hansenii strain differed significantly from that of the reference strain within each mold species, a Dunnett’s test was performed using GraphPad Prism v9 (Dotmatics, Boston, Massachusetts, USA). Graphs were prepared in Microsoft Excel, and the corresponding significance levels were added to each plot. Statistically significant differences are indicated as follows: p < 0.05 (*), p < 0.01 (**), and p < 0.001 (***).
To evaluate whether the antifungal activity of D. hansenii was influenced by the culture medium, yeast strain, and mold species, a three-way analysis of variance (ANOVA) was performed, with Medium (PDA vs. LBM), Strain (CBS767, LR2, SRF1, CB1), and Mold species (A. flavus, P. echinulatum, P. rubens, P. crustosum) as fixed factors. Interaction terms (Medium x Strain, Medium x Mold, and Medium x Strain x Mold) were included to determine whether the effect of the medium varied depending on strain and/or mold species. When significant effects were detected, Šidák’s multiple comparisons test was applied to identify differences between specific factor combinations. Assumptions of normality and homogeneity of variance were assessed using Q–Q plots of residuals and Levene’s test, respectively. These analyses were carried out using JASP (v0.95; University of Amsterdam, The Netherlands).
3. Results
3.1. Inhibitory Potential of Debaryomyces hansenii Against Spoilage Molds on PDA Media
After 10 days of incubation at 26 °C, strong antifungal activity was observed across all tested
D. hansenii strains (CBS767, CB1, LR2, SRF1) against the four mold species evaluated on PDA plates:
A. flavus,
P. echinulatum,
P. rubens, and
P. crustosum. Macroscopic inspection revealed an evident reduction in mold growth in yeast-treated conditions compared to the untreated controls (
Figure 1).
In the case of
A. flavus (
Figure 1a), the control plate exhibited dense and expansive mycelial growth, completely covering the surface, whereas the co-inoculated condition showed severely restricted mold development. Although not as visually impactful, the diminish in mycelial expansion was also clear for
P. echinulatum (
Figure 1b),
P. rubens (
Figure 1c), and
P. crustosum (
Figure 1d), where yeast-treated plates exhibited fragmented, irregular, and diminished mycelial patterns compared to the controls. These visual results support the potent antagonistic activity of
D. hansenii against spoilage mold on rich nutrient laboratory media.
Quantitative assessment of the antifungal activity is shown in
Figure 2, where inhibition percentages for each
D. hansenii strain are presented across the four mold species.
The highest inhibition was observed against
A. flavus (
Figure 2a), with all yeast strains reaching inhibition percentages above 98%. For the remaining mold species (
P. echinulatum,
P. rubens, and
P. crustosum;
Figure 2b–d), inhibition values ranged from 85% to 97%, indicating a consistently high antifungal performance across all yeast strains.
Notably, strain LR2 achieved the greatest inhibitory activity overall, with inhibition levels exceeding 93% against P. echinulatum (93.77%), P. rubens (94.57%), and P. crustosum (97.10%). In most cases, no statistically significant differences were observed between the native isolates and the reference strain CBS767 ut for CB1 strain against P. rubens, which, although low, showcased significantly lower inhibition from a 93% in CBS767 to 88% in CB1. Altogether, these results underscore the robust and uniform antifungal potential of D. hansenii under standard rich nutrient media and laboratory conditions.
3.2. Inhibitory Potential of Debaryomyces hansenii Against Spoilage Molds on Meat-Derived Media
To better simulate the cured meat environment, the antagonistic activity of
D. hansenii was further assessed on LBM. Although the overall inhibition percentages were lower than those determined in PDA, clear antifungal activity was still detected (
Figure 3).
In the control plates (top row of each panel), fungi exhibited vigorous radial expansion typical of their growth under nutrient-rich conditions. In contrast, the yeast-treated plates (bottom row) showed visibly reduced mycelial development across all tested fungi. The most pronounced inhibition was observed in panel (b and d), where P. echinolatum and P. crustosum growth was visibly diminished. In panel (a), A. flavus still showed moderate development, suggesting that its suppression may be more influenced by medium composition. These results support that D. hansenii maintains its antagonistic activity in meat-like substrates, although matrix complexity and nutrient availability likely modulate the extent of inhibition.
Quantitative assessment of the antifungal activity is shown in
Figure 4, where inhibition percentages for each
D. hansenii strain are presented across the four mold species.
Overall, antifungal activity was maintained under these more complex matrix conditions, although the magnitude of inhibition varied depending on the mold species and yeast strain. Inhibition percentages ranged from 50% to 100%, with greater variability observed compared to PDA assays.
For
A. flavus (
Figure 4a), all strains achieved inhibition levels above 70%, with LR2 strain exhibiting significantly higher activity (100%) than the reference strain CBS767 (
p < 0.05). In contrast, most strains inhibited
P. echinulatum (
Figure 4b) uniformly and strongly (>95%), with a lower inhibition (88%,
p < 0.001) observed in strain CB1. Inhibition of
P. rubens (
Figure 4c) was lower and more heterogeneous, ranging from ~52% to ~64%, with SRF1 displaying the most consistent and robust inhibition, though differences were not statistically significant. For
P. crustosum (
Figure 4d), inhibition ranged from ~70 to 96%, with CB1 showing the highest mean value (100%,
p < 0.05). These results confirmed that
D. hansenii retains antifungal activity under meat-like conditions. However, despite maintaining its inhibitory capacity, the efficacy varied depending on the culture media used, highlighting the influence of the substrate composition on the biocontrol performance.
3.3. Influence of the Culture Medium on the Antifungal Performance of Debaryomyces hansenii
The three-way ANOVA, with Medium (PDA vs. LBM), Strain (CBS767, LR2, SRF1, CB1), and Mold species (
A. flavus,
P. echinulatum,
P. rubens,
P. crustosum) as fixed factors, revealed that the main effect of Medium was significant (
p < 0.001), indicating that, overall, the type of culture medium influenced the antifungal activity of
D. hansenii (
Table 2). Yeast strain did not have a significant main effect (
p = 0.204), whereas Mold species showed a strong effect (
p < 0.001), confirming that the target fungus markedly affected inhibition levels.
Among the interactions, Medium x Yeast strain (p = 0.031), Medium x Mold (p < 0.001) and Medium x Yeast strain x Mold (p = 0.001) were significant, while Yeast strain x Mold (p = 0.179) were not. This pattern indicates that the effect of the medium was not uniform across all conditions: the magnitude and direction of the medium effect varied depending on the mold species, the strain of D. hansenii, and, in some cases, their specific combination.
Post-hoc Šidák’s tests confirmed that inhibition was significantly higher on PDA than on LBM for P. rubens (p < 0.001) and P. crustosum (p = 0.048), whereas no significant differences between media were observed for A. flavus and P. echinulatum. The magnitude of these differences was also strain-dependent in certain mold species. For instance, LR2 D. hansenii strain showed the largest drop in inhibition against P. rubens when moving from PDA to LBM, whereas CBS767 maintained similar inhibition levels against A. flavus across both media.
4. Discussion
D. hansenii is a yeast with remarkable physiological versatility [
19,
35] and a multifactorial mode of action as a biocontrol agent [
6,
7]. Its antagonistic capacity against molds is not limited to a single mechanism but rather involves multiple strategies, including competition for nutrients and space, biofilm formation, the production of VOCs, and the synthesis of specific mycocins [
22,
23,
24,
25,
26]. This diversity of mechanisms may act synergistically or differentially depending on environmental conditions, making it reasonable to assume that, in complex matrices such as those derived from meat, certain mechanisms may lose prominence while others may become more relevant.
As all scientific studies whose goal is to bring novelty to industry, laboratory-scale assays are needed before scaling up processes. Often enough, this type of study, although promising, ends up not being suitable for a bigger scale, turning this into a waste of resources and time. Laboratory assay reliability depends on the ability to simulate industrial conditions and on the use of appropriate validation and monitoring tools. Predictions are more accurate when models and devices specifically designed to reflect the complexity of industrial processes are employed [
36,
37,
38].
D. hansenii biocontrol potential-related studies usually employ standardized laboratory culture media that allow results to be compared and mechanisms of inhibition to be understood. One of the most widely used synthetic media in fungi-related studies is PDA [
39,
40,
41,
42,
43,
44] being also frequently used medium in
D. hansenii biocontrol assays [
4,
6,
17,
22].
The results of this study, supported by the three-way ANOVA presented in
Table 2, show that the culture medium had a significant overall effect on the antifungal efficacy of
D. hansenii (
p < 0.001), and that the Medium × Yeast strain interaction was also significant (
p = 0.031), indicating that the effect of the medium varied across strains when averaged over all molds. The main effect of Yeast strain was not significant (
p = 0.204). Under synthetic conditions using PDA media, all strains of this study exhibited strong inhibitory activity against spoilage molds, with inhibition rates exceeding 85%, and particularly high performance by LR2 strain, which achieved over 93% inhibition. This behavior was consistent with previous studies reporting the ability of
D. hansenii to inhibit the growth of toxigenic molds in nutrient-rich media such as PDA [
4,
6,
17,
22]. However, when simulating conditions closer to the actual food environment by using a medium composed of 20% meat (LBM), the antifungal efficacy was generally reduced. This confirms that the growth substrate is a primary driver of antifungal performance in this system, with potential implications for industrial-scale applications. The effect of the medium was not uniform across all molds, as indicated by the significant Medium x Mold interaction (
p < 0.001), and in specific cases also varied depending on the strain–mold combination, as reflected in the significant Medium × Yeast strain × Mold interaction (
p = 0.001). Significant reductions in inhibition were observed for
P. rubens and
P. crustosum in the LBM medium, while inhibition against
A. flavus and
P. echinulatum remained comparable to PDA. Despite this,
D. hansenii’s strains maintained moderate to high inhibition levels, reinforcing their applied potential. These findings confirm that biocontrol performance in PDA does not necessarily predict performance in a meat-based medium, and highlight that the relative ranking of strains can change depending on the growth substrate, target mold and their interaction with the yeast strain tested. This variability supports the inclusion of food-derived or matrix-mimicking media in early screening stages, as results from synthetic systems may overestimate the true antagonistic potential of candidate strains.
Despite the general reduction in inhibitory activity observed in the meat-derived media compared to the synthetic medium (PDA), the inhibition levels remain relevant in an applied context. The maintenance of inhibitory activity above 50% against spoilage molds in a complex matrix such as cured meat suggests that these yeasts hold real potential as protective cultures. This discrepancy between synthetic and food-like media in
D. hansenii studies is not unique to our findings. García-Bramasco et al. [
45] demonstrated that
D. hansenii embedded in chitosan-based films showed strong antifungal activity against
Penicillium italicum, but the effectiveness varied with matrix composition. This observation echoes findings by Huang et al. [
9], who noted that VOC-mediated inhibition by
D. hansenii strains varied significantly across dairy matrices. Consequently, this supports the idea, already observed in earlier studies [
46,
47,
48,49], that functional assays using food-simulating matrices should be an essential part of the selection and validation process for promising protective cultures prior its application in the industry.
As repeatedly reported in the literature, one of the main struggles in the study of
D. hansenii and its applications is its high variability among strains [
20,
21]. This study underscores that when applying meat-like matrices, this variability becomes less marked, turning this matrix more effective and reliable to scale up to practical applications. Consequently, validating biocontrol performance in food-like systems emerges as a superior strategy, ensuring a more precise selection of strains that can genuinely contribute to enhancing food safety and shelf life in meat products.
Overall, this study demonstrates that D. hansenii has strong potential as a biocontrol agent against spoilage molds in dry-cured meat products. The dual-phase evaluation strategy employed in this study, combining synthetic and meat-derived media, highlights the importance of assessing antifungal efficacy under conditions that closely mimic the final product environment. All autochthonous strains evaluated, especially SRF1 and LR2, proved capable of maintaining substantial inhibitory activity even in a meat-derived media, reinforcing their value as candidates for future technological applications in the meat industry.
5. Conclusions
The findings of this study provide new evidence supporting the potential of D. hansenii as a biocontrol agent against spoilage molds in dry-cured meat products. All tested strains exhibited strong inhibitory activity in synthetic media, with strain LR2 showing the highest inhibition rates. Although a general decrease in efficacy was observed in the meat-derived medium, D. hansenii’s strains maintained considerable inhibitory capacity, highlighting their relevance for practical applications.
The significant effect of the culture medium, together with yeast strain and mold interactions, demonstrates that antifungal efficacy is strongly influenced by both the composition of the growth matrix and the specific strain–mold combination. While synthetic media remain valuable for initial screenings and mechanistic studies, they should not be the sole basis for selecting biocontrol agents. The integration of food-simulating matrices provides a more accurate representation of matrix-dependent and strain-specific interactions and enhances the reliability of strain selection. Our findings emphasize the importance of including food-mimicking systems in the early stages of biocontrol screening to better predict performance in real food environments. Accordingly, we recommend incorporating representative food-based media in early phases of biocontrol strategy development to ensure more realistic and effective strain selection.
Altogether, this work identifies promising native D. hansenii strains with consistent biocontrol potential under conditions that closely resemble the dry-cured meat production process. Their application as protective cultures could contribute to improving the safety and shelf life of these traditional products, offering a more natural and consumer-friendly alternative to chemical preservatives.
Author Contributions
Conceptualization, F.J.R.-C., A.L.P.-F. and J.R.; methodology, F.J.R.-C., A.L.P.-F. and P.I.V.-R.; software, F.J.R.-C., A.L.P.-F., P.I.V.-R and H.C.-N.; validation, F.J.R.-C., H.C.-N. and J.R.; formal analysis, F.J.R.-C., A.L.P.-F. and J.R.; investigation, A.L.P.-F., P.I.V.-R. and F.J.R.-C.; resources, J.R.; writing—original draft preparation, F.J.R.-C. and H.C-N.; writing—review and editing, F.J.R.-C., H.C.-N. and J.R.; visualization, F.J.R-C. and H.C.-N.; supervision, J.R.; project administration, J.R.; funding acquisition, J.R. All authors have read and agreed to the published version of the manuscript.
Funding
This work was supported by Plan Propio de Investigación, University of Córdoba 2025.
Data Availability Statement
The data supporting the findings of this work are available within the paper.
Acknowledgments
The authors sincerely thank Navalpedroche S.L., for its support.
Conflicts of Interest
The authors declare no conflicts of interest.
References
- Núñez, F.; Lara, M.S.; Peromingo, B.; Delgado, J.; Sánchez-Montero, L.; Andrade, M.J. Selection and evaluation of Debaryomyces hansenii isolates as potential bioprotective agents against toxigenic penicillia in dry-fermented sausages. Food microbiol. 2015, 46, 114–120. [CrossRef]
- Freimoser, F.M.; Rueda-Mejia, M.P.; Tilocca, B. et al. Biocontrol yeasts: mechanisms and applications. World J. Microbiol. Biotechnol. 2019, 35, 154 (2019). [CrossRef]
- Chen, O.; Hong, Y.; Ma, J.; Deng, L.; Yi, L.; Zeng, K. Screening lactic acid bacteria from pickle and cured meat as biocontrol agents of Penicillium digitatum on citrus fruit. Biol. Control, 2021, 158, 104606. [CrossRef]
- Chacón-Navarrete, H.; Ruiz-Pérez, F.; Ruiz-Castilla, F.J.; Ramos, J. Exploring Biocontrol of Unwanted Fungi by Autochthonous Debaryomyces hansenii Strains Isolated from Dry Meat Products. JoF, 2022, 8(8), 873. [CrossRef]
- Sipiczki, M. (2023). Identification of antagonistic yeasts as potential biocontrol agents: Diverse criteria and strategies. Int. J.f Food Microbiol. 2023, 406, 110360. [CrossRef]
- Medina-Córdova, N.; López-Aguilar, R.; Ascencio, F.; Castellanos, T.; Campa-Córdova, A.I.; Angulo, C. Biocontrol activity of the marine yeast Debaryomyces hansenii against phytopathogenic fungi and its ability to inhibit mycotoxins production in maize grain (Zea mays L.). Biol. Control, 2016, 97, 70–79. [CrossRef]
- Medina-Córdova, N.; Rosales-Mendoza, S.; Hernández-Montiel, L.G.; Angulo, C. The potential use of Debaryomyces hansenii for the biological control of pathogenic fungi in food. Biol. Control, 2018, 121, 216–222. [CrossRef]
- Kowalska, J.; Krzymińska, J.; Tyburski, J. Yeasts as a Potential Biological Agent in Plant Disease Protection and Yield Improvement—A Short Review. Agriculture, 2022, 12(9), 1404. [CrossRef]
- Huang, C.; Zhang, L.; Johansen, P.G.; Petersen, M.A.; Arneborg, N.; Jespersen, L. Debaryomyces hansenii Strains Isolated From Danish Cheese Brines Act as Biocontrol Agents to Inhibit Germination and Growth of Contaminating Molds. Front. Microbiol. 2021, 12, 662785. [CrossRef]
- Ramos, J.; Melero, Y.; Ramos-Moreno, L.; Michán, C.; Cabezas, L. Debaryomyces hansenii Strains from Valle De Los Pedroches Iberian Dry Meat Products: Isolation, Identification, Characterization, and Selection for Starter Cultures. J Microbiol. Biotechnol. 2017, 27(9), 1576–1585. [CrossRef]
- Belloch, C.; Perea-Sanz, L.; Gamero, A.; Flores, M. Selection of Debaryomyces hansenii isolates as starters in meat products based on phenotypic virulence factors, tolerance to abiotic stress conditions and aroma generation. J. Appl. Microbiol. 2022, 133(1), 200–211. [CrossRef]
- Prista, C.; Almagro, A.; Loureiro-Dias, M.C.; Ramos, J. Physiological basis for the high salt tolerance of Debaryomyces hansenii. Appl. Environ, Microbiol. 1997, 63(10), 4005–4009. [CrossRef]
- Michán, C.; Martínez, J.L.; Alvarez, M.C.; Turk, M.; Sychrova, H.; Ramos, J. Salt and oxidative stress tolerance in Debaryomyces hansenii and Debaryomyces fabryi. FEMS Yeast Res. 2013, 13(2), 180–188. [CrossRef]
- Corral, S.; Salvador, A.; Belloch, C.; Flores, M. Effect of fat and salt reduction on the sensory quality of slow fermented sausages inoculated with Debaryomyces hansenii yeast. Food Control, 2014, 45, 1–7. [CrossRef]
- Prista, C.; Michán, C.; Miranda, I.M.; Ramos, J. The halotolerant Debaryomyces hansenii, the Cinderella of non-conventional yeasts. Yeast (Chichester, England), 2016, 33(10), 523–533. [CrossRef]
- Ruiz-Pérez, F.S.; Ruiz-Castilla, F.J.; Leal, C.; Martínez, J.L.; Ramos, J. Sodium and lithium exert differential effects on the central carbon metabolism of Debaryomyces hansenii through the glyoxylate shunt regulation. Yeast (Chichester, England), 2023, 40(7), 265–275. [CrossRef]
- Chacón-Navarrete, H.; Gómez, M.; Cardador, M.J.; Salatti-Dorado, J.Á.; Pérez-Cacho, P.R.; Roldán-Casas, J.Á.; Arce, L.; Galán-Soldevilla, H.; López, B.; Ramos, J.; Ruiz-Castilla, F J. The antimycotic potential of Debaryomyces hansenii LRC2 on Iberian Pork Loins with low concentration preservatives. Food Control, 2024, 165, 110632. [CrossRef]
- Ochoa-Gutiérrez, D.; Reyes-Torres, A.M.; de la Fuente-Colmenares, I.; Escobar-Sánchez, V.; González, J.; Ortiz-Hernández, R.; Torres-Ramírez, N.; Segal-Kischinevzky, C. Alternative CUG Codon Usage in the Halotolerant Yeast Debaryomyces hansenii: Gene Expression Profiles Provide New Insights into Ambiguous Translation. JoF, 2022, 8(9), 970. [CrossRef]
- Lépingle, A.; Casaregola, S.; Neuvéglise, C.; Bon, E.; Nguyen, H.; Artiguenave, F.; Wincker, P.; Gaillardin, C. Genomic exploration of the hemiascomycetous yeasts: 14. Debaryomyces hansenii var. hansenii. FEBS Lett. 2000, 487(1), 82–86. [CrossRef]
- Petersen, K.M.; Jespersen, L. Genetic diversity of the species Debaryomyces hansenii and the use of chromosome polymorphism for typing of strains isolated from surface-ripened cheeses. J. Appl. Microbiol. 2004, 97(1), 205–213. [CrossRef]
- Jacques, N.; Sacerdot, C.; Derkaoui, M.; Dujon, B.; Ozier-Kalogeropoulos, O.; Casaregola, S. Population polymorphism of nuclear mitochondrial DNA insertions reveals widespread diploidy associated with loss of heterozygosity in Debaryomyces hansenii. Eukaryot. Cell 2010, 9(3), 449–459. [CrossRef]
- Chacón-Navarrete, H.; García-Álvarez de Toledo, I.; Ramos, J.; Ruiz-Castilla, F.J. Evaluating the Role of Nutrient Competition in Debaryomyces hansenii Biocontrol Activity Against Spoilage Molds in the Meat Industry. JoF, 2025, 11(4), 242. [CrossRef]
- EFSA Panel on Biological Hazards (BIOHAZ), Koutsoumanis, K.; Allende, A.; Alvarez-Ordóñez, A.; Bolton, D.; Bover-Cid, S.; Chemaly, M.; De Cesare, A.; Hilbert, F.; Lindqvist, R.; Nauta, M.; Peixe, L.; Ru, G.; Simmons, M.; Skandamis, P.; Suffredini, E.; Cocconcelli, P.S.; Escámez, P.S.F.; Maradona, M.P.; … Herman, L. Update of the list of qualified presumption of safety (QPS) recommended microbiological agents intentionally added to food or feed as notified to EFSA 17: suitability of taxonomic units notified to EFSA until September 2022 [JB]. EFSA Journal, 2023, 21(1). [CrossRef]
- Núñez, F.; Lara, M.S.; Peromingo, B.; Delgado, J.; Sánchez-Montero, L.; Andrade, M.J. Selection and evaluation of Debaryomyces hansenii isolates as potential bioprotective agents against toxigenic penicillia in dry-fermented sausages. Food Microbiol. 2015, 46, 114–120. [CrossRef]
- Hernández-Montiel, L.G.; Larralde-Corona, C.P.; Vero, S.; López-Aburto, M.G.; Ochoa, J.L.; Ascencio-Valle, F. Characterization of yeast Debaryomyces hansenii for the biological control of blue mold decay of Mexican lemon. CyTA – J. Food 2010, 8(1), 49–56. [CrossRef]
- Iacumin, L.; Manzano, M.; Andyanto, D.; Comi, G. Biocontrol of ochratoxigenic moulds (Aspergillus ochraceus and Penicillium nordicum) by Debaryomyces hansenii and Saccharomycopsis fibuligera during speck production. Food Microbiol. 2017, 62, 188–195. [CrossRef]
- Andrade, M.J.; Delgado, J.; Rodríguez, M.; Núñez, F.; Córdoba, J.J.; Peromingo, B. Mycotoxins in meat products. Meat Sci. 2025, 227, 109850. [CrossRef]
- Banjara, N.; Nickerson, K.W.; Suhr, M.J.; Hallen-Adams, H.E. Killer toxin from several food-derived Debaryomyces hansenii strains effective against pathogenic Candida yeasts. Int. J. Food Microbiol. 2016, 222, 23–29. [CrossRef]
- Al-Qaysi, S.A.S.; Al-Haideri, H.; Thabit, Z.A.; Al-Kubaisy, W.H.A.A.; Ibrahim, J.A.A. Production, Characterization, and Antimicrobial Activity of Mycocin Produced by Debaryomyces hansenii DSMZ70238. Int. J. Food Microbiol. 2017, 2605382. [CrossRef]
- Çorbacı, C.; Uçar, F.B. Purification, characterization and in vivo biocontrol efficiency of killer toxins from Debaryomyces hansenii strains. Int. J. Biol. Macromol. 2018, 119, 1077–1082. [CrossRef]
- Połomska, X.; Neuvéglise, C.; Zyzak, J.; Żarowska, B.; Casaregola, S.; Lazar, Z. New Cytoplasmic Virus-Like Elements (VLEs) in the Yeast Debaryomyces hansenii. Toxins 2021, 13(9), 615. [CrossRef]
- Peromingo, B.; Núñez, F.,; Rodríguez, A.; Alía, A.; Andrade, M.J. Potential of yeasts isolated from dry-cured ham to control ochratoxin A production in meat models. Int. J. Food Microbiol., 2018, 268, 73–80. [CrossRef]
- Van Veen, S.Q.; Claas, E.C.; Kuijper, E.J. High-throughput identification of bacteria and yeast by matrix-assisted laser desorption ionization-time of flight mass spectrometry in conventional medical microbiology laboratories. J. Clin. Microbiol. 2010, 48, 900–907. [CrossRef]
- Usyk, M.; Zolnik, C.P.; Patel, H.; Levi, M.H.; Burk, R.D. Novel ITS1 Fungal Primers for Characterization of the Mycobiome. mSphere, 2017, 2(6), e00488-17. [CrossRef]
- Breuer, U.; Harms, H. Debaryomyces hansenii — an extremophilic yeast with biotechnological potential. Yeast 2006, 23(6), 415–437. [CrossRef]
- Connelly, S.; Shin, S.G.; Dillon, R.J.; Ijaz, U.Z.; Quince, C.; Sloan, W.T., Collins, G. Bioreactor Scalability: Laboratory-Scale Bioreactor Design Influences Performance, Ecology, and Community Physiology in Expanded Granular Sludge Bed Bioreactors. Front. Microbiol. 2017, 8. [CrossRef]
- Zieringer, J.; Takors, R. In Silico Prediction of Large-Scale Microbial Production Performance: Constraints for Getting Proper Data-Driven Models. CSBJ, 2018, 16, 246–256. [CrossRef]
- Miyake, D.; Kanaya, S.; Ono, N. Statistical Modeling of Within-Laboratory Precision Using a Hierarchical Bayesian Approach. J. AOAC Int. 2024, 107(6), 960–970. [CrossRef]
- Devi, K.S.; Misra D.K.; Saha, J.; Devi, Ph.S.; Sinha, B. Screening of Suitable Culture Media for Growth, Cultural and Morphological Characters of Pycnidia Forming Fungi. Int. J. Curr. Microbiol. App. Sci. 2018, 7(8): 4207-4214. [CrossRef]
- Permadi, M.A.; Mukhlis; Samosir, B.S.; Siregar, D.Y.; Wayni, M. Physiology Characterization of Entomopathogenic Fungi Beauveria bassiana and Metarhizium anisopliae on Different Carbohydrate Sources. JPCS, 2020, 1477(7), 072007. [CrossRef]
- Dzhagan, V.; Krupodorova, T.; Atamanchuk, A.; Lytvynenko, Y.; Dzhagan, V. Growth and morphological characteristics of some pyrophilous discomycetes in culture. Biosyst. Divers. 2023, 31(3), 282–289. [CrossRef]
- Kumar, M.; Ratan, V.; Chaurasiya, A.; Singh, V.; Kumar, N.; Singh, P.; Pratap, G.; Verma, B. In-vitro assessment of different culture of media on the isolation and purification of cauliflower alternaria leaf spot disease caused by Alternaria brassicicola (Schwein). Int. J. Plant Sci. 2023, 35 (20):1060-68. [CrossRef]
- Cheng, C.-Y.; Zhang, M.-Y.; Niu, Y.-C.; Zhang, M.; Geng, Y.-H.; Deng, H. Comparison of fungal genera isolated from cucumber plants and rhizosphere soil by using various cultural media. JoF 2023, 9(9), 934. [CrossRef]
- Zhang, F.; Li, M.; Tian, J.; Ge, X.; Li, S.; Chen, J.; Li, Y.; Zhang, Y. Isolation and identification of spoilage fungi in potato fresh wet vermicelli and inhibition effect of different fungicides on spoilage fungi. JoF, 2025, 11(5), 367. [CrossRef]
- García-Bramasco, C. A.; Blancas-Benitez, F.J.; Montaño-Leyva, B.; Medrano-Castellón, L.M.; Gutierrez-Martinez, P.; González-Estrada, R.R. Influence of marine yeast Debaryomyces hansenii on antifungal and physicochemical properties of chitosan-based films. JoF, 2022, 8(4), 369. [CrossRef]
- Peromingo, B.; Rodríguez, A.; Bernáldez, V.; Delgado, J.; Rodríguez, M. Effect of temperature and water activity on growth and aflatoxin production by Aspergillus flavus and Aspergillus parasiticus on cured meat model systems. Meat Sci. 2016, 122, 76–83. [CrossRef]
- Peromingo, B.; Núñez, F.; Rodríguez, A.; Alía, A.; Andrade, M.J. Potential of yeasts isolated from dry-cured ham to control ochratoxin A production in meat models. Int. J. Food Microbiol. 2018, 268, 73–80. [CrossRef]
- Peromingo, B.; Andrade, M.J.; Delgado, J.; Sánchez-Montero, L.; Núñez, F. Biocontrol of aflatoxigenic Aspergillus parasiticus by native Debaryomyces hansenii in dry-cured meat products. Food Microbiol. 2019, 82, 269–276. [CrossRef]
|
Disclaimer/Publisher’s Note: The statements, opinions and data contained in all publications are solely those of the individual author(s) and contributor(s) and not of MDPI and/or the editor(s). MDPI and/or the editor(s) disclaim responsibility for any injury to people or property resulting from any ideas, methods, instructions or products referred to in the content. |
© 2025 by the authors. Licensee MDPI, Basel, Switzerland. This article is an open access article distributed under the terms and conditions of the Creative Commons Attribution (CC BY) license (http://creativecommons.org/licenses/by/4.0/).